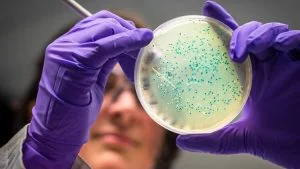
الكشف عن حل طبيعي فعال لمتلازمة القولون العصبي

حققت الدراسات السريرية نجاحًا كبيرًا ،حول علاج متلازمة القولون العصبي التي يعاني منها حوالي 15 بالمائة من الأشخاص في تركيا.
ووفق الدراسات السريرية التي أجرتها شركة رائدة محلية للتكنولوجيا الحيوية تعمل على تطوير برامج التغذية الشخصية من خلال تحليل البكتيريا في الأمعاء البشرية عبر اختبارات الميكروبيوم ، لوحظ تحسنا ملحوظا في الأعراض لدى 78 في المائة من المرضى ،وفق ترجمة تركيا الآن.
وقال المسؤول أوزكان أفق نالبانت أوغلو: “في المرحلة الأولى من الدراسات التي أجريناها بموافقة لجنة الأخلاقيات في جامعة غازي ، تم جمع عينات من البراز من المرضى وتحليل الميكروبيوم.
بالتزامن مع نتائج الدراسة ، تابعت اللجنة الحالة السريرية للمرضى لمدة 6 أسابيع من قبل أخصائي أمراض الجهاز الهضمي، قبل وبعد اتباع نظام غذائي”.
وتابع قوله :” في نهاية الدراسة ، لوحظ تحسناً واضحاً ذات دلالة إحصائية في المجموعة التي خضعت لنظام غذائي خاص مقارنة بالمجموعة التي خضعت للنظام الغذائي القياسي”.
وأشار أوغلو إلى إفادة خبراء أمراض الجهاز الهضمي بأن 78 في المائة من مجموعة النظام الغذائي الخاص بالشركة كانت لديهم أعراض شديدة في بداية الدراسة ، بينما كان لدى جميع المرضى أعراض حادة. وبالمثل ، كانت هناك تغييرات كبيرة في ملف تعريف الميكروبيوم للمرضى في مجموعة النظام الغذائي الخاص مقارنة بالمجموعة الأخرى.
وأكد على ضرورة الإعلان عن هذه النتائج في المجال العلمي في أسرع وقت ممكن، مشيراً إلى أنه تم كتابة المقالة المتعلقة كفريق ، وتجهيز خطة لتقديم النتائج في مؤتمر دولي قبل النشر.
ومن الجدير ذكره لا زالت الأبحاث الجارية حول علاقة البكتيريا في الأمعاء ، والتي تسمى عناصر الميكروبيوم ، بصحة الإنسان، تتواصل في جميع أنحاء العالم.
ووفق لتقارير محلية حققت الدراسات المحلية في تركيا، نجاحاً كبيراً من خلال مبادرات التكنولوجيا الحيوية التي تهدف إلى تطوير حلول صحية مخصصة لعلاج العديد من المشاكل الصحية مثل السمنة والسكري والأكزيما ، من خلال البكتيريا الموجودة في الأمعاء البشرية، عبر الدراسات السريرية القائمة حول متلازمة القولون العصبي.
أعلن وزير العدل التركي، أكين غورلَك، عن تفاصيل وجدول التوظيف لـ 15 ألف موظف جديد…
كشفت وسائل إعلام إسرائيلية عن نجاح الرئيس التركي رجب طيب أردوغان في إقناع الرئيس الأمريكي…
أعلن الرئيس التركي، رجب طيب أردوغان، عن قرارين اقتصاديين بارزين يهدفان إلى إعطاء زخم…
أعلنت الإدارة الأمريكية رسمياً أن الرئيس دونالد ترامب سيحضر شخصياً قمة حلف شمال الأطلسي…
بدأت السلطات التركية تطبيق خطة أمنية استثنائية لحماية سماء العاصمة أنقرة وتأمين قمة حلف شمال…
انتقد الرئيس التركي رجب طيب أردوغان بشدة أزمة القيادة والصراع الداخلي المحتدم داخل حزب…
هذا الموقع يستعمل ملفات تعريف الارتباط (الكوكيز) لتحسين تجربة استخدامك.